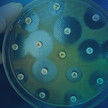
Sonderregel für DocMorris / Phoenix: Kein Wiederaufbau / Widerrufsrecht bei Versendern / Antibiotika

adhoc24
adhoc24 vom 3.12.25 Pleite trotz Millionen / Overwiening: „Nichts mehr zu verlieren“ / Reform im Kabinett / Wundprodukte
Easy-Apotheker Markus Vivell leidet unter den höheren Ausgaben. Ein Grund für die Insolvenz sind jedoch „Altlasten“, wie der 53-Jährige sagt. / Der vdek kommt... Mehr»
adhoc24 vom 2.12.25 Philippi: Keine Hamsterkäufe / PTA-Schule schließt / Anstieg bei Rezeptfälschungen / Rezeptur-Urteil
Ermittler sehen einen drastischen Anstieg bei Fällen von gefälschten Rezepten. Dabei gehe es nahezu ausschließlich um als Abnehmspritzen bekanntgewordene... Mehr»
adhoc24 vom 1.12.25 Gerlach: ApoVWG nachbessern / Kassen verklagen Bund / Engpass-Bevorratung / Grüne: Keine Homöopathie
„Die geplante Apothekenreform des Bundes braucht dringend Nachbesserungen“, sagt Bayerns Gesundheitsministerin Judith Gerlach von der CSU. Die Apotheken... Mehr»
adhoc24 vom 28.11.25 Jeder zweite Kunde pöbelt / Error 404 / Überwachung aus dem Mülleimer / Polizei sperrt Apotheke zu
Viele Fachkräfte bekommen immer wieder verbale Ausbrüche der Kundschaft zu spüren. Pöbeleien sind an der Tagesordnung. / Der Protest für ein höheres... Mehr»
adhoc24 vom 27.11.2025 Polizei schließt Apotheke / Fake-Rezept / CSU unterstützt höheres Fixum / Pilsinger Berichterstatter
Unterstützung für die Apotheken für eine Erhöhung des Fixums kommt aus Bayern. / In Frankfurt am Main hat die Polizei eine Apotheke geschlossen. Dies geschah... Mehr»
adhoc24 vom 26.11.2025 Pöbeleien in Apotheken / Resolution / Selbstmedikation stärken / Korrupter Oberstaatsanwalt
Acht Stunden im Handverkauf können zermürben. Denn viele Fachkräfte bekommen immer wieder verbale Ausbrüche der Kundschaft zu spüren. / Die Apotheker:innen in... Mehr»
adhoc24 vom 25.11.25 Mehr Raubüberfälle / Inhaber gewinnt gegen Kasse / ePA braucht Stabilität / BDA will Apothekenketten
Die Gematik meldete heute morgen 9 Uhr eine Störung bei der elektronischen Patientenakte. Die ePA brauche Stabilität, um ihren Mehrwert zu entfalten, so die... Mehr»
adhoc24 vom 24.11.2025 DocMorris filmt Angestellte / Merck warnt vor Betrügern / 35 km bis zur Notdienstapotheke / 404
Bei DocMorris in Heerlen entdeckte ein Angestellter per Zufall eine versteckte Kamera in einem Mülleimer. Schockiert berichtete er dem Betriebsrat davon, doch... Mehr»
adhoc24 vom 21.11.2025 DocMorris: Länderliste als Bumerang? / HBA-Chaos / Apothekengipfel in MV / Phoenix ohne Freiburg
Der Massentausch von elektronischen Heilberufsausweisen führt in Apotheken und Arztpraxen zu massivem Chaos und Frust. Manche Apothekeninhaber müssen sich sogar... Mehr»
adhoc24 vom 20.11.2025 Honorarforderungen: Gespräche laufen noch / Tiktok: Notdienst geht viral / TI-Chaos
Beim Apothekengipfel in Mecklenburg-Vorpommern haben die Apothekerinnen und Apotheker ein klares Signal an die CDU gesendet. Verbandschef Markus Oelze erwartet... Mehr»
adhoc24 vom 19.11.2025 Mini-Protest in MW / Fragen an Warken / Sechs Tage keine E-Rezepte / Kein EC-Wechsel wegen Cannabis
Die CDU stellt sich den Apotheken: Die gesundheitspolitische Sprecherin Simone Borchardt lädt in ihrem Wahlkreis in Mecklenburg-Vorpommern zu einer... Mehr»
adhoc24 vom 18.11.25 Sonderregel für DocMorris / Phoenix: Kein Wiederaufbau / Widerrufsrecht bei Versendern / Antibiotika
Eigentlich hatte DocMorris schon vor drei Jahren vom Oberlandesgericht Düsseldorf (OLG) einen Freibrief bekommen, was den Nachweis einer öffentlichen Apotheke... Mehr»